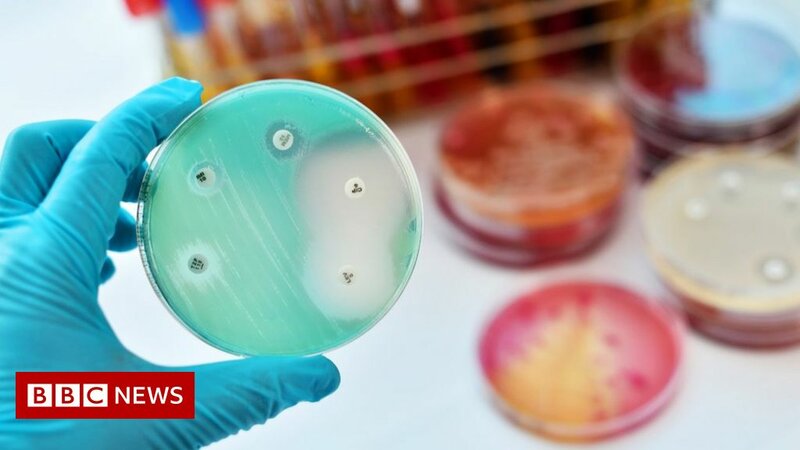

Posted on Jan 20, 2022
Millions are dying from drug-resistant infections, global report says
1.79K
8
3
5
5
0
Posted 4 y ago
Responses: 2
Lt Col John (Jack) Christensen
You'd think doctors would have figured that out, but I'm told by a retired pediatrician that it's often easier to agree with parents demand for antibiotics than explain why they shouldn't be used.
(0)
(0)
Nothing new, we lost a neighbor almost 7 years ago who went to hospital for routine surgery, contracted MRSA and passed about a month later.
(0)
(0)
Read This Next

Health
Health


